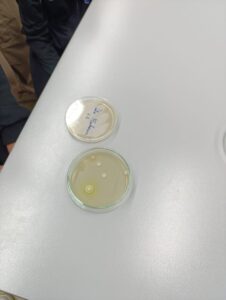

U sklopu nastave prirode i biologije učenici od petog do osmog razreda pod vodstvom su nastavnice Monike Pavić, profesorice biologije, i Ivane Pavlin, školske knjižničarke, posjetili mikrobiološki laboratorij na „Prehrambeno tehnološkom fakultetu“ u Osijeku.
Učenici su se upoznali s osnovama rada u laboratorijskim uvjetima i svijetom mikroorganizama. Učili su o pravilima sigurnosti u laboratoriju, promatrali preparate pod mikroskopom, izrađivali vlastite preparate te mikroskopirali uzorke iz prirode. Također su s mikrobiolozima razgovarali o važnosti mikroorganizama u svakodnevnom životu.
Posebno zanimljivo bilo je mikroskopiranje bakterijskih stanica kojim su učenici mogli vlastitim očima vidjeti svijet oku nevidljiv. Tako su ove aktivnosti povezali s projektom „Zdravo odrastanje“ u koji je naša škola uključena.
Ovaj posjet bio je odlična prilika za povezivanje teorijskog znanja s praktičnim iskustvom te je kod učenika pobudio još veće zanimanje za prirodoslovlje.
Zahvaljujemo gospođi Ani Škorvaga na gostoprimstvu i organizaciji ovog posjeta te se veselimo novim znanstvenim pustolovinama!
Monika Pavić